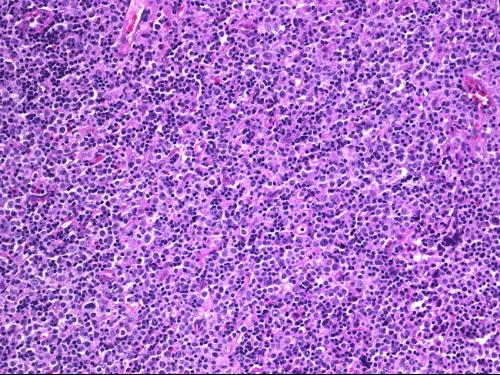

灵芝破壁孢子粉为什么能够抑制肿瘤
灵芝破壁孢子粉为什么能够抑制肿瘤,众所周知灵芝孢子粉能够提升免疫力,而提高免疫力是灵芝破壁孢子粉抑制肿瘤最主要的作用机制之一。
人类机体免疫系统中的T淋巴细胞、巨噬细胞、NK细胞、K细胞、B细胞等都有杀伤、抑制肿瘤细胞的能力。细胞因子、免疫因子TNF、IFN-γ、IL-I、IL-Ⅱ、IL-Ⅲ,溶酶体、NO等能协助免疫细胞对肿瘤细胞的杀伤作用。
菇新灵芝破壁孢子粉专家发现T淋巴细胞在第一次接触到肿瘤抗原后就产生了识别肿瘤细胞的记忆,并能迅速繁殖出大量的小T细胞,包围攻击肿瘤细胞,将其抑制或杀死。
T-淋巴细胞
而之前菇新灵芝提到的巨噬细胞能将肿瘤细胞吞噬,并能把肿瘤细胞的抗原传递给其他免疫细胞,使得其他免疫细胞具有识别肿瘤细胞的能力。NK细胞能不经抗原诱导,直接识别、杀伤肿瘤细胞。与巨噬细胞不同的是B淋巴细胞在接到巨噬细胞传给的肿瘤细胞表面抗原后'能迅速分裂繁殖大量的小B淋巴细胞——浆细胞,浆细胞会分泌抗体。抗体能与肿瘤细胞表面的抗原发生反应,从而起到杀伤肿瘤细胞的作用。
在研究中菇新破壁灵芝孢子粉发现免疫系统中的肿瘤坏死因子TNF-ct能使肿瘤细胞的细胞膜溶解,使肿瘤细胞凋亡;干扰素IFN一γ能干扰肿瘤细胞DNA的合成,从而抑制肿瘤的生长繁殖;IL一工、IL-Ⅱ有延长淋巴细胞生命周期;IL一Ⅲ有直接破坏肿瘤细胞结构、杀伤肿瘤细胞的功效。溶酶体能使被吞噬的肿瘤细胞膜溶解,NO有杀伤肿瘤细胞的作用。
破壁灵芝孢子粉有提高机体免疫力的作用:提高T淋巴细胞转化能力,迅速增加T细胞数量;提高T4/T8细胞比值;使T细胞的杀伤能力增强;提高巨噬细胞吞噬肿瘤细胞的能力,使巨噬细胞的变形、运动能力,包围、吞噬肿瘤细胞的能力提高,增加产生溶酶体和No的量,使巨噬细胞吞噬指数提1~3倍,吞噬百分率提高50%--100%;
菇新在研究中发现:灵芝破壁孢子粉可使NK细胞的数量提高25%左右,并提高NK细胞杀伤肿瘤细胞的能力;破壁灵芝孢子粉能提高浆细胞产生抗体的能力;灵芝可使血清TNF-α、IFN-γ、IL-I、IL-Ⅱ的水平提高25%~30%,NO分泌量提高13.2%。

菇新灵芝破壁孢子粉抑制肿瘤
所以灵芝孢子粉可通过全面提高机体免疫功能,实现对肿瘤细胞生长的抑制和杀伤,这也就是灵芝孢子粉的功效与作用中影响意义最大的一点。
最新产品
同类文章排行
- 破壁灵芝孢子粉的用量及其服用方法介绍
- 破壁灵芝孢子粉吃完会拉肚子吗
- 破壁灵芝孢子粉的服用剂量介绍说明
- 你知道破壁灵芝孢子粉的日常保健效果有哪些吗
- 为什么有的人不能吃灵芝孢子粉 什么原因
- 吃破壁灵芝孢子粉会中毒吗?有哪些副作用?
- 说一说女人长期吃破壁灵芝孢子粉的好处
- 双十一大促破壁灵芝孢子粉的价格会便宜吗
- 生活中正确服用破壁灵芝孢子粉的方法有哪些
- 破壁灵芝孢子粉有降血糖的作用吗
最新资讯文章
您的浏览历史







 沪公网安备31012002005858号
沪公网安备31012002005858号
